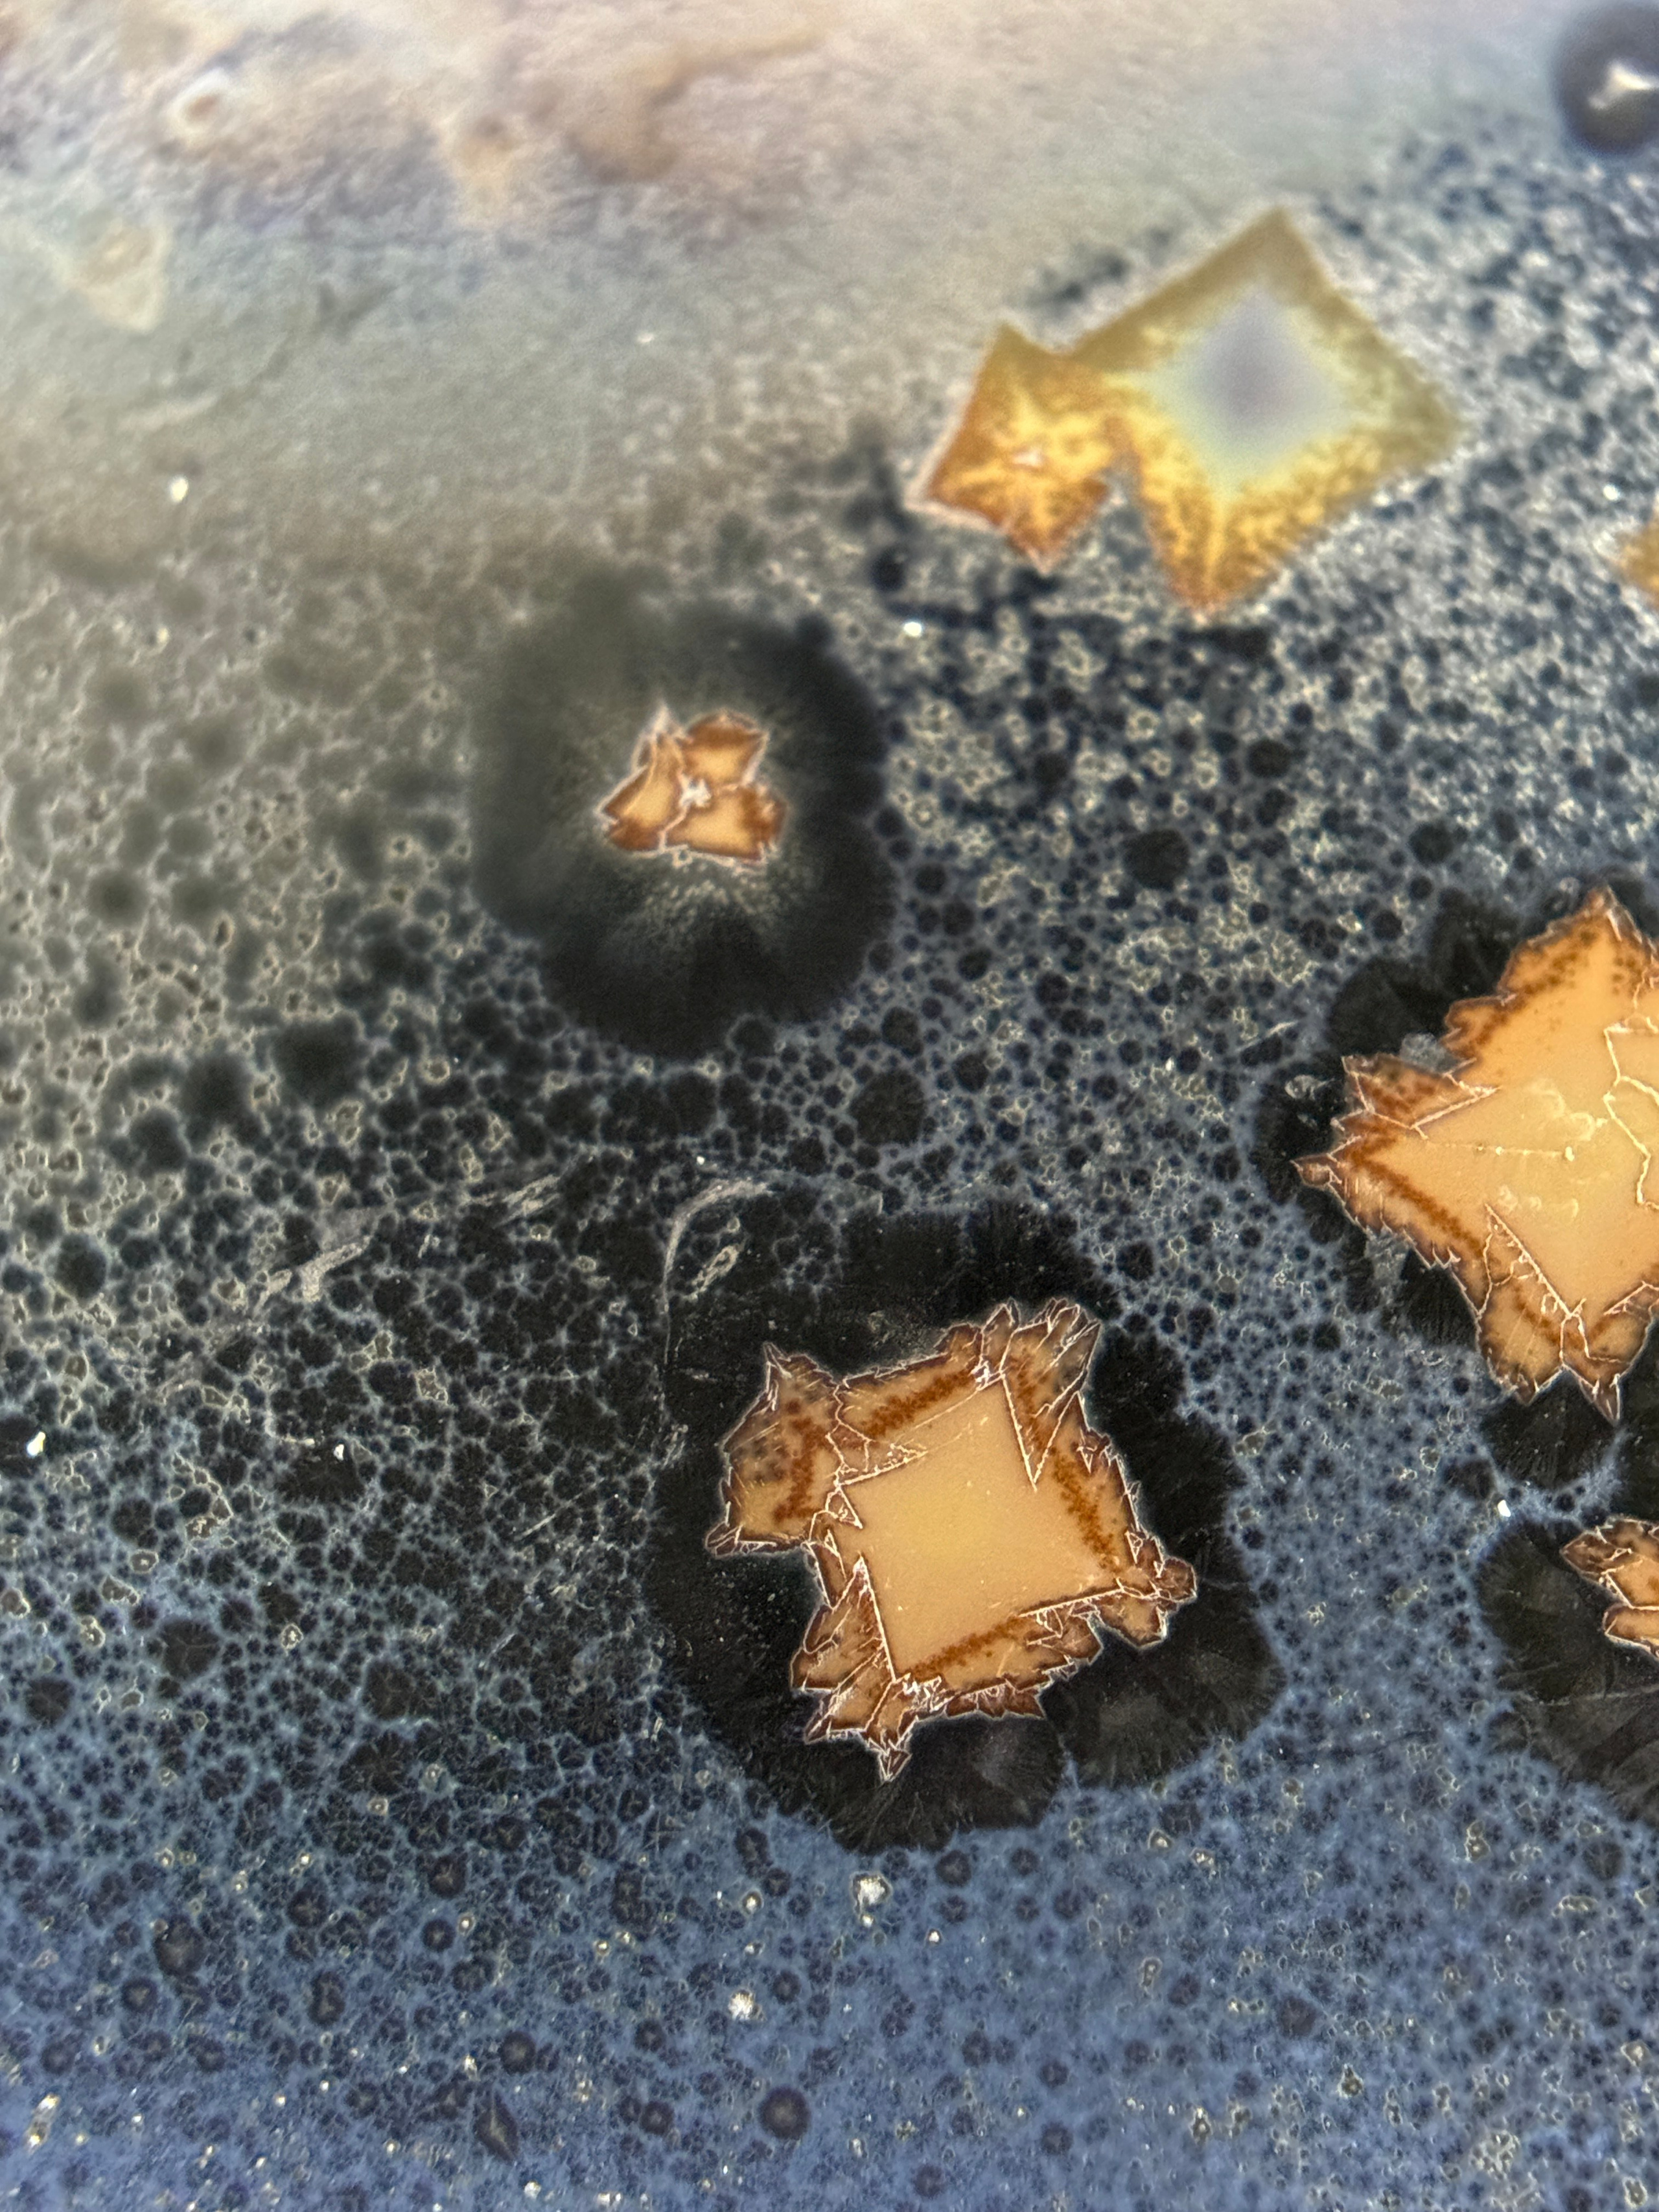
Curriculum Vitae. Артур Бахтин

Образование
Профессиональная переподготовка по специальности «Художественная керамика», МГХПА им. Строганова по специальности «Художественная керамика», Москва 2018 — 2019
Магистратура в МГХПА им. Строганова на кафедре «Художественная керамика» по направлению «студийная керамика», МГХПА им. Строганова, Москва 2019 — 2021
Тема магистерской работы: «Эстетика агрессии в художественной керамике XX–XXI вв.»
с 2021- по н. в. — преподает «Технологию и материаловедение», а также «Новые тенденции и технологии керамики» в МГХПА им. Строганов на кафедре «Художественная керамика»

«Объект F60.8» как итог исследования магистерской работы на тему:
«Эстетика агрессии в художественной керамике XX–XXI вв.»
Керамика для меня — одновременно вызов и открытие. На первый взгляд материал кажется податливым, обещающим безграничные возможности. Тем не менее, при ближайшем рассмотрении он оказывается притязательным, требующим преданности процессу. Каждое изделие представляет собой тщательное исследование границ глины, глазури и техник обжига. Эксперименты с глазурями служат средством расширения художественной палитры, позволяя мне исследовать фактуру, цвет, отечность, цветовые отклики. Тем не менее, с каждым годом меня все сильнее тянет к простоте, замечает красоту в самом материале. Минимализм возник для меня как естественное развитие, как ответ на ошеломляющий приток информации в современном обществе. В мире, перенасыщенном стимулами и визуальными образами, я ищу спокойствие в минимализме — пространстве, где я могу отдохнуть глазами и сознанием. Мои объекты — результат моей борьбы за контроль над материалом. В каждом проекте я сталкиваюсь с извечным вопросом: контролирую ли я глину или она контролирует меня?